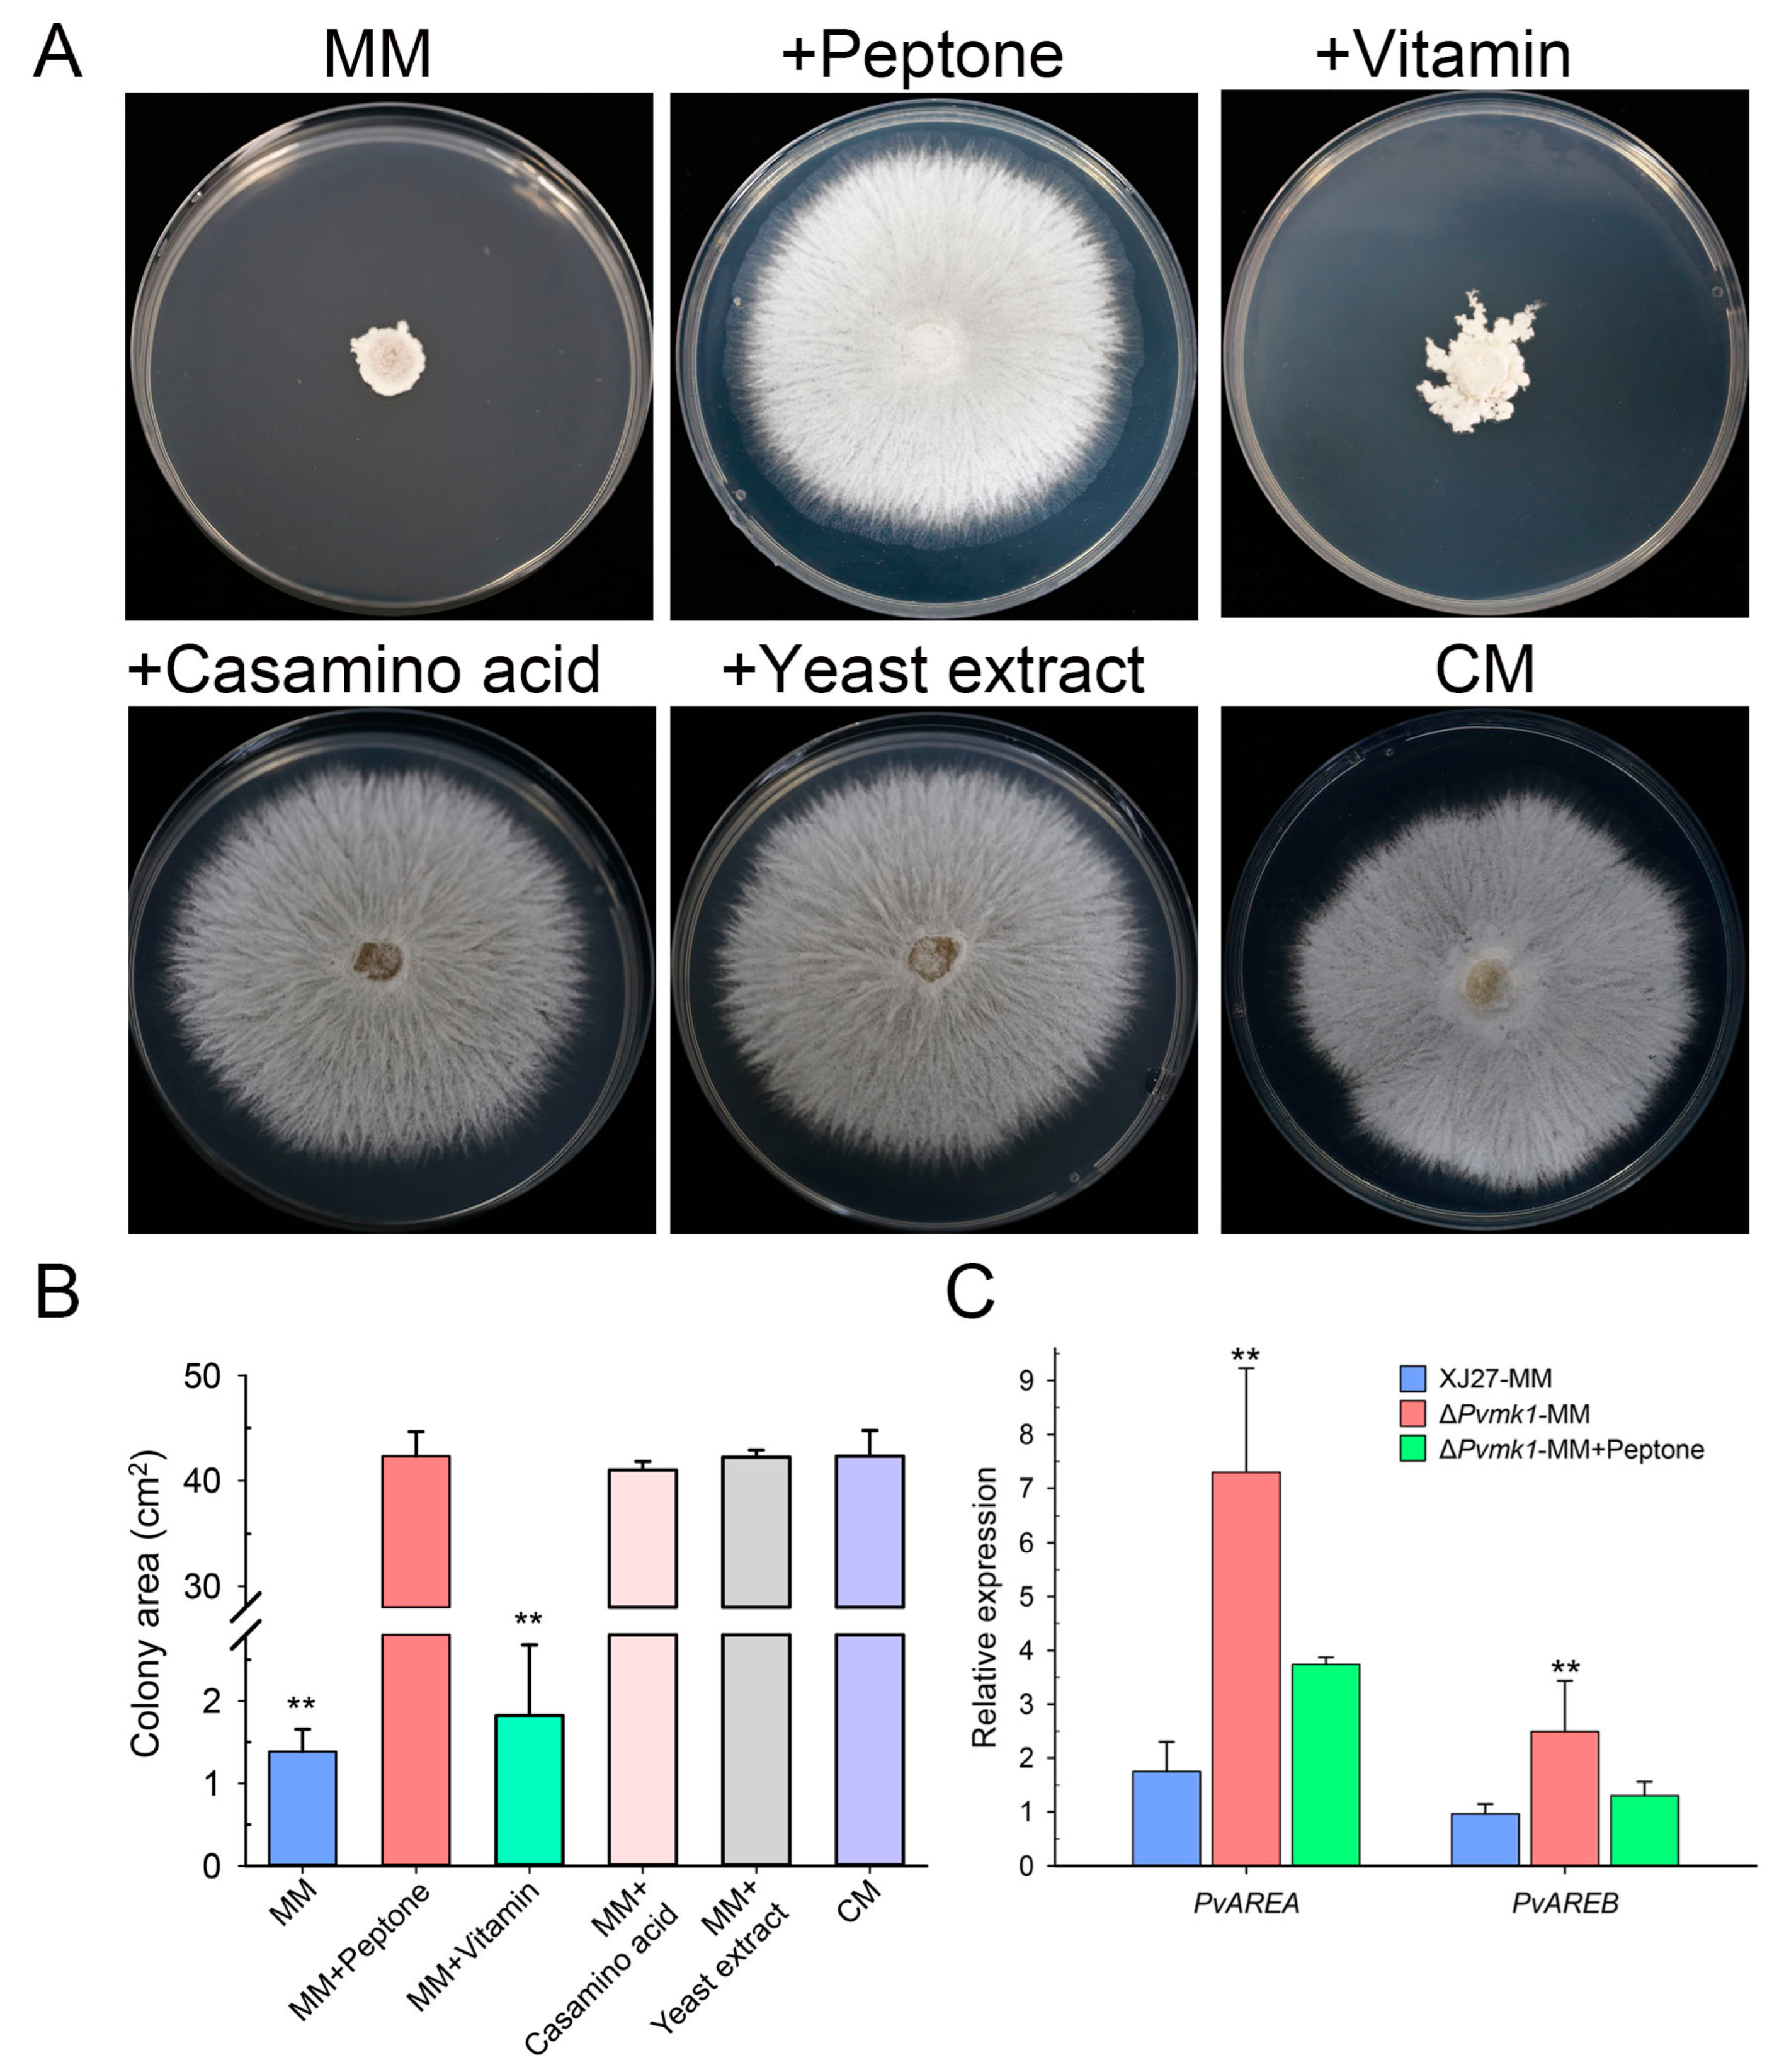
Jof 09 00606 g003

The MAP Kinase PvMK1 Regulates Hyphal Development, Autophagy, and Pathogenesis in the Bayberry Twig Blight Fungus Pestalotiopsis versicolor
Abstract
1. Introduction
2. Materials and Methods
2.1. Fungal Strains and Culture Conditions
2.2. Genome Sequencing and Annotation
2.3. Targeted Gene Deletion and Complementation
2.4. Phenotypic Analysis
2.5. Virulence Assays
2.6. Quantitative Real-Time PCR (qRT-PCR)
2.7. Western Blot and MAPK Phosphorylation Assays
2.8. Autophagy Assays
2.9. Statistical Analysis
3. Results
3.1. Genome Sequencing of P. versicolor Strain XJ27 and Functional Annotation
3.2. Identification of PvMk1 and Targeted Gene Deletion
3.3. PvMk1 Is Required for Hyphal Development and Conidiation
3.4. PvMk1 Regulates Nitrogen Stress Responses Required for P. versicolor Hyphal Development
3.5. PvMk1 Is Critical for P. versicolor Virulence on Bayberry
3.6. PvMk1 Is Involved in P. versicolor Responses to Environmental Stress Conditions
3.7. PvMk1 Is Required for P. versicolor Autophagy under Nutrient-Depleting Conditions
4. Discussion
5. Conclusions
Supplementary Materials
Author Contributions
Funding
Institutional Review Board Statement
Informed Consent Statement
Data Availability Statement
Acknowledgments
Conflicts of Interest
References
- Chen, K.; Xu, C.; Zhang, B.; Ferguson, I.B. Red Bayberry: Botany and Horticulture. Horti. Rev. 2004, 30, 83–114. [Google Scholar] [CrossRef]
- Ren, H.; Yu, H.; Zhang, S.; Liang, S.; Zheng, X.; Zhang, S.; Yao, P.; Zheng, H.; Qi, X. Genome sequencing provides insights into the evolution and antioxidant activity of Chinese bayberry. BMC Genom. 2019, 20, 458. [Google Scholar] [CrossRef] [PubMed]
- Zhang, S.; Yu, Z.; Q, X.; Wang, Z.; Zheng, Y.; Ren, H.; Liang, S.; Zheng, X. Construction of a High-Density Genetic Map and Identification of Leaf Trait-Related QTLs in Chinese Bayberry (Myrica rubra). Front. Plant Sci. 2021, 12, 675855. [Google Scholar] [CrossRef]
- Sun, C.; Huang, H.; Xu, C.; Li, X.; Chen, K. Biological Activities of Extracts from Chinese Bayberry (Myrica rubra Sieb. et Zucc.): A Review. Plant Foods Hum. Nutr. 2013, 68, 97–106. [Google Scholar] [CrossRef]
- Kang, W.; Li, Y.; Xu, Y.; Jiang, W.; Tao, Y. Characterization of aroma compounds in Chinese bayberry (Myrica rubra Sieb. et Zucc.) by gas chromatography mass spectrometry (GC-MS) and olfactometry (GC-O). J. Food Sci. 2012, 77, C1030–C1035. [Google Scholar] [CrossRef]
- Chen, W.; Zhou, S.; Zheng, X. A new function of Chinese bayberry extract: Protection against oxidative DNA damage. LWT 2015, 60, 1200–1205. [Google Scholar] [CrossRef]
- Zhang, S.; Yu, Z.; Sun, L.; Ren, H.; Zheng, X.; Liang, S.; Qi, X. An overview of the nutritional value, health properties, and future challenges of Chinese bayberry. PeerJ 2022, 10, e13070. [Google Scholar] [CrossRef]
- Zheng, Y.; Yu, Z.; Li, Y.; Zhong, S.; Sun, Y.; Sun, L.; Zheng, X.; Qi, X.; Zhang, S. Alcohol extracts of Chinese bayberry branch induce S-phase arrest and apoptosis in HepG2 cells. Food Sci. Nut. 2022, 11, 493–503. [Google Scholar] [CrossRef]
- Ren, H.; Li, G.; Qi, X.; Wei, W.J.; Liang, S.M.; Zheng, X.L.; Yan, L.J.; Zhu, X.T. Biological characteristics of Pestalotiopsis versicolor, the agent of bayberry twig blight in Southern China. Acta. Agric. Zhejiangensis. 2013, 25, 1309–1320. [Google Scholar]
- Ren, H.-Y.; Li, G.; Qi, X.-J.; Fang, L.; Wang, H.-R.; Wei, J.-G.; Zhong, S. Identification and characterization of Pestalotiopsis spp. causing twig blight disease of bayberry (Myrica rubra Sieb. & Zucc) in China. Eur. J. Plant Pathol. 2013, 137, 451–461. [Google Scholar] [CrossRef]
- Bhuiyan, M.A.B.; Islam, S.M.N.; Bukhari, M.A.I.; Kader, M.A.; Chowdhury, M.Z.H.; Alam, M.Z.; Abdullah, H.M.; Jenny, F. First Report of Pestalotiopsis microspora Causing Leaf Blight of Banana in Bangladesh. Plant Dis. 2022, 106, 1518. [Google Scholar] [CrossRef] [PubMed]
- Espargham, N.; Mohammadi, H.; Gramaje, D. A Survey of Trunk Disease Pathogens within Citrus Trees in Iran. Plants 2020, 9, 754. [Google Scholar] [CrossRef] [PubMed]
- Wang, S.; Mi, X.; Wu, Z.; Zhang, L.; Wei, C.; Zheng, S.; Chen, R.; Wang, Z.; Liu, J.; Cai, Y.; et al. Characterization and Pathogenicity of Pestalotiopsis-Like Species Associated with Gray Blight Disease on Camellia sinensis in Anhui Province, China. Plant Dis. 2019, 103, 2786–2797. [Google Scholar] [CrossRef] [PubMed]
- Liyanapathiranage, P.; Avin, F.A.; Swiggart, E.; Lopez, E.F.; Parajuli, M.; Oksel, C.; Gao, Y.; Baysal-Gurel, F. First Report of Leaf Spot of Panax quinquefolius Caused by Pestalotiopsis nanjingensis in Tennessee and the United States. Plant Dis. 2023, 1943–7692. [Google Scholar] [CrossRef]
- Jiang, C.; Zhang, X.; Liu, H.; Xu, J.-R. Mitogen-activated protein kinase signaling in plant pathogenic fungi. PLoS Pathog. 2018, 14, e1006875. [Google Scholar] [CrossRef] [PubMed]
- Engelberg, D.; Perlman, R.; Levitzki, A. Transmembrane signaling in Saccharomyces cerevisiae as a model for signaling in metazoans: State of the art after 25years. Cell. Signal. 2014, 26, 2865–2878. [Google Scholar] [CrossRef]
- Xu, J.R.; Hamer, J.E. MAP kinase and cAMP signaling regulate infection structure formation and pathogenic growth in the rice blast fungus Magnaporthe grisea. Genes Dev. 1996, 10, 2696–2706. [Google Scholar] [CrossRef]
- Turrà, D.; Segorbe, D.; Di Pietro, A. Protein Kinases in Plant-Pathogenic Fungi: Conserved Regulators of Infection. Annu. Rev. Phytopathol. 2014, 52, 267–288. [Google Scholar] [CrossRef]
- González-Rubio, G.; Sellers-Moya, A.; Martín, H.; Molina, M. A walk-through MAPK structure and functionality with the 30-year-old yeast MAPK Slt2. Int. Microbiol. 2021, 24, 531–543. [Google Scholar] [CrossRef]
- Xu, J.-R.; Staiger, C.J.; Hamer, J.E. Inactivation of the mitogen-activated protein kinase Mps1 from the rice blast fungus prevents penetration of host cells but allows activation of plant defense responses. Proc. Natl. Acad. Sci. USA 1998, 95, 12713–12718. [Google Scholar] [CrossRef]
- Brewster, J.L.; de Valoir, T.; Dwyer, N.D.; Winter, E.; Gustin, M.C. An Osmosensing Signal Transduction Pathway in Yeast. Science 1993, 259, 1760–1763. [Google Scholar] [CrossRef] [PubMed]
- Zheng, D.; Zhang, S.; Zhou, X.; Wang, C.; Xiang, P.; Zheng, Q.; Xu, J.-R. The FgHOG1 Pathway Regulates Hyphal Growth, Stress Responses, and Plant Infection in Fusarium graminearum. PLoS ONE 2012, 7, e49495. [Google Scholar] [CrossRef]
- Segmüller, N.; Ellendorf, U.; Tudzynski, B.; Tudzynski, P. BcSAK1, a stress-activated mitogen-activated protein kinase, is in-volved in vegetative differentiation and pathogenicity in Botrytis cinerea. Eukaryot. Cell 2007, 6, 211–221. [Google Scholar] [CrossRef] [PubMed]
- Dixon, K.P.; Xu, J.-R.; Smirnoff, N.; Talbot, N.J. Independent Signaling Pathways Regulate Cellular Turgor during Hyperosmotic Stress and Appressorium-Mediated Plant Infection by Magnaporthe grisea. Plant Cell 1999, 11, 2045–2058. [Google Scholar] [CrossRef] [PubMed]
- Wang, Y.; Tian, L.; Xiong, D.; Klosterman, S.J.; Xiao, S.; Tian, C. The mitogen-activated protein kinase gene, VdHog1, regulates osmotic stress response, microsclerotia formation and virulence in Verticillium dahliae. Fungal Genet. Biol. 2016, 88, 13–23. [Google Scholar] [CrossRef] [PubMed]
- Kojima, K.; Takano, Y.; Yoshimi, A.; Tanaka, C.; Kikuchi, T.; Okuno, T. Fungicide activity through activation of a fungal sig-nalling pathway. Mol. Microbiol. 2004, 53, 1785–1796. [Google Scholar] [CrossRef]
- Liu, Z.; Jian, Y.; Chen, Y.; Kistler, H.C.; He, P.; Ma, Z.; Yin, Y. A phosphorylated transcription factor regulates sterol biosynthesis in Fusarium graminearum. Nat. Commun. 2019, 10, 1–17. [Google Scholar] [CrossRef] [PubMed]
- Bohnert, S.; Heck, L.; Gruber, C.; Neumann, H.; Distler, U.; Tenzer, S.; Yemelin, A.; Thines, E.; Jacob, S. Fungicide resistance toward fludioxonil conferred by overexpression of the phosphatase gene MoPTP2 in Magnaporthe oryzae. Mol. Microbiol. 2019, 111, 662–677. [Google Scholar]
- Segorbe, D.; Di Pietro, A.; Pérez-Nadales, E.; Turrà, D. Three Fusarium oxysporum mitogen-activated protein kinases (MAPKs) have distinct and complementary roles in stress adaptation and cross-kingdom pathogenicity. Mol. Plant Pathol. 2017, 18, 912–924. [Google Scholar] [CrossRef]
- Li, G.; Zhang, X.; Tian, H.; Choi, Y.; Tao, W.A.; Xu, J. MST50 is involved in multiple MAP kinase signaling pathways in Magnaporthe oryzae. Environ. Microbiol. 2017, 19, 1959–1974. [Google Scholar] [CrossRef]
- Yu, G.; Klionsky, D.J. Life and Death Decisions—The Many Faces of Autophagy in Cell Survival and Cell Death. Biomolecules 2022, 12, 866. [Google Scholar] [CrossRef] [PubMed]
- Talbot, N.J.; Kershaw, M.J. The emerging role of autophagy in plant pathogen attack and host defence. Curr. Opin. Plant Biol. 2009, 12, 444–450. [Google Scholar] [CrossRef] [PubMed]
- Nakatogawa, H. Mechanisms governing autophagosome biogenesis. Nat. Rev. Mol. Cell Biol. 2020, 21, 439–458. [Google Scholar] [CrossRef]
- Zhu, X.-M.; Li, L.; Wu, M.; Liang, S.; Shi, H.-B.; Liu, X.-H.; Lin, F.-C. Current opinions on autophagy in pathogenicity of fungi. Virulence 2018, 10, 481–489. [Google Scholar] [CrossRef]
- Veneault-Fourrey, C.; Barooah, M.; Egan, M.; Wakley, G.; Talbot, N.J. Autophagic fungal cell death is necessary for infection by the rice blast fungus. Science 2006, 312, 580–583. [Google Scholar] [CrossRef] [PubMed]
- Ebbole, D.; Mj, K.; Nj, T. Faculty Opinions recommendation of Genome-wide functional analysis reveals that infection-associated fungal autophagy is necessary for rice blast disease. Proc. Natl. Acad. Sci. USA 2009, 106, 15967–15972. [Google Scholar] [CrossRef]
- Josefsen, L.; Droce, A.; Sondergaard, T.E.; Sørensen, J.L.; Bormann, J.; Schäfer, W.; Giese, H.; Olsson, S. Autophagy provides nutrients for nonassimilating fungal structures and is necessary for plant colonization but not for infection in the necrotrophic plant pathogen Fusarium graminearum. Autophagy 2012, 8, 326–337. [Google Scholar] [CrossRef]
- Lv, W.; Wang, C.; Yang, N.; Que, Y.; Talbot, N.J.; Wang, Z. Genome-wide functional analysis reveals that autophagy is necessary for growth, sporulation, deoxynivalenol production and virulence in Fusarium graminearum. Sci. Rep. 2017, 7, 11062. [Google Scholar] [CrossRef]
- Corral-Ramos, C.; Roca, M.G.; Di Pietro, A.; Roncero, M.I.G.; Ruiz-Roldán, C. Autophagy contributes to regulation of nuclear dynamics during vegetative growth and hyphal fusion in Fusarium oxysporum. Autophagy 2015, 11, 131–144. [Google Scholar] [CrossRef]
- Ren, W.; Liu, N.; Sang, C.; Shi, D.; Zhou, M.; Chen, C.; Qin, Q.; Chen, W. The Autophagy Gene BcATG8 Regulates the Vegetative Differentiation and Pathogenicity of Botrytis cinerea. Appl. Environ. Microbiol. 2018, 84, e02455-17. [Google Scholar] [CrossRef]
- Asakura, M.; Ninomiya, S.; Sugimoto, M.; Oku, M.; Yamashita, S.-I.; Okuno, T.; Sakai, Y.; Takano, Y. Atg26-Mediated Pexophagy Is Required for Host Invasion by the Plant Pathogenic Fungus Colletotrichum orbiculare. Plant Cell 2009, 21, 1291–1304. [Google Scholar] [CrossRef] [PubMed]
- Osés-Ruiz, M.; Cruz-Mireles, N.; Martin-Urdiroz, M.; Soanes, D.M.; Eseola, A.B.; Tang, B.; Derbyshire, P.; Nielsen, M.; Cheema, J.; Were, V.; et al. Appressorium-mediated plant infection by Magnaporthe oryzae is regulated by a Pmk1-dependent hierarchical transcriptional network. Nat. Microbiol. 2021, 6, 1383–1397. [Google Scholar] [CrossRef] [PubMed]
- Walker, B.J.; Abeel, T.; Shea, T.; Priest, M.; Abouelliel, A.; Sakthikumar, S.; Cuomo, C.A.; Zeng, Q.; Wortman, J.; Young, S.K.; et al. Pilon: An Integrated Tool for Comprehensive Microbial Variant Detection and Genome Assembly Improvement. PLoS ONE 2014, 9, e112963. [Google Scholar] [CrossRef] [PubMed]
- Su, W.; Ou, S.; Hufford, M.B.; Peterson, T. A Tutorial of EDTA: Extensive De Novo TE Annotator. Methods Mol. Biol. 2021, 2250, 55–67. [Google Scholar] [CrossRef] [PubMed]
- Brůna, T.; Hoff, K.J.; Lomsadze, A.; Stanke, M.; Borodovsky, M. BRAKER2: Automatic eukaryotic genome annotation with GeneMark-EP+ and AUGUSTUS supported by a protein database. NAR Genom. Bioinform. 2021, 3, lqaa108. [Google Scholar] [CrossRef]
- Seppey, M.; Manni, M.; Zdobnov, E.M. BUSCO: Assessing Genome Assembly and Annotation Completeness. Methods Mol. Biol. 2019, 1962, 227–245. [Google Scholar] [CrossRef] [PubMed]
- Mullins, E.D.; Chen, X.; Romaine, P.; Raina, R.; Geiser, D.M.; Kang, S. Agrobacterium-Mediated Transformation of Fusarium oxysporum: An Efficient Tool for Insertional Mutagenesis and Gene Transfer. Phytopathology 2001, 91, 173–180. [Google Scholar] [CrossRef]
- Zhou, L.; Zhao, J.; Guo, W.; Zhang, T. Functional Analysis of Autophagy Genes via Agrobacterium-Mediated Transformation in the Vascular Wilt Fungus Verticillium dahliae. J. Genet. Genom. 2013, 40, 421–431. [Google Scholar] [CrossRef]
- Bustin, S.A. Absolute quantification of mRNA using real-time reverse transcription polymerase chain reaction assays. J. Mol. Endocrinol. 2000, 25, 169–193. [Google Scholar] [CrossRef]
- Cai, Y.Y.; Wang, J.Y.; Wu, X.Y.; Liang, S.; Zhu, X.M.; Li, L.; Lu, J.P.; Liu, X.H.; Lin, F.C. MoOpy2 is essential for fungal devel-opment, pathogenicity, and autophagy in Magnaporthe oryzae. Environ. Microbiol. 2022, 24, 1653–1671. [Google Scholar] [CrossRef]
- Li, X.; Gao, C.; Li, L.; Liu, M.; Yin, Z.; Zhang, H.; Zheng, X.; Wang, P.; Zhang, Z. MoEnd3 regulates appressorium formation and virulence through mediating endocytosis in rice blast fungus Magnaporthe oryzae. PLoS Pathog. 2017, 13, e1006449. [Google Scholar] [CrossRef] [PubMed]
- Talbot, N.J. Fungal genomics goes industrial. Nat. Biotechnol. 2007, 25, 542–543. [Google Scholar] [CrossRef] [PubMed]
- Slater, G.S.C.; Birney, E. Automated generation of heuristics for biological sequence comparison. BMC Bioinform. 2005, 6, 31. [Google Scholar] [CrossRef] [PubMed]
- Teufel, F.; Armenteros, J.J.A.; Johansen, A.R.; Gíslason, M.H.; Pihl, S.I.; Tsirigos, K.D.; Winther, O.; Brunak, S.; von Heijne, G.; Nielsen, H. SignalP 6.0 predicts all five types of signal peptides using protein language models. Nat. Biotechnol. 2022, 40, 1023–1025. [Google Scholar] [CrossRef]
- Emanuelsson, O.; Nielsen, H.; Brunak, S.; von Heijne, G. Predicting Subcellular Localization of Proteins Based on their N-terminal Amino Acid Sequence. J. Mol. Biol. 2000, 300, 1005–1016. [Google Scholar] [CrossRef]
- Mueller, O.; Kahmann, R.; Aguilar, G.; Trejo-Aguilar, B.; Wu, A.; de Vries, R.P. The secretome of the maize pathogen Ustilago maydis. Fungal Genet. Biol. 2008, 45, S63–S70. [Google Scholar] [CrossRef]
- Eseola, A.B.; Ryder, L.S.; Osés-Ruiz, M.; Findlay, K.; Yan, X.; Cruz-Mireles, N.; Molinari, C.; Garduño-Rosales, M.; Talbot, N.J. Investigating the cell and developmental biology of plant infection by the rice blast fungus Magnaporthe oryzae. Fungal Genet. Biol. 2021, 154, 103562. [Google Scholar] [CrossRef]
- Fan, R.; Klosterman, S.J.; Wang, C.; Subbarao, K.V.; Xu, X.; Shang, W.; Hu, X. Vayg1 is required for microsclerotium formation and melanin production in Verticillium dahliae. Fungal Genet. Biol. 2017, 98, 1–11. [Google Scholar] [CrossRef]
- Tudzynski, B. Nitrogen regulation of fungal secondary metabolism in fungi. Front. Microbiol. 2014, 5, 656. [Google Scholar] [CrossRef]
- Kim, H.; Woloshuk, C. Role of AREA, a regulator of nitrogen metabolism, during colonization of maize kernels and fumonisin biosynthesis in Fusarium verticillioides. Fungal Genet. Biol. 2008, 45, 947–953. [Google Scholar] [CrossRef]
- Wilson, R.A.; Talbot, N.J. Under pressure: Investigating the biology of plant infection by Magnaporthe oryzae. Nat. Rev. Microbiol. 2009, 7, 185–195. [Google Scholar] [CrossRef] [PubMed]
- Sanz, A.B.; García, R.; Rodríguez-Peña, J.M.; Arroyo, J. The CWI Pathway: Regulation of the Transcriptional Adaptive Response to Cell Wall Stress in Yeast. J. Fungi 2018, 4, 1. [Google Scholar] [CrossRef] [PubMed]
- González-Rubio, G.; Sastre-Vergara, L.; Molina, M.; Martín, H.; Fernández-Acero, T. Substrates of the MAPK Slt2: Shaping Yeast Cell Integrity. J. Fungi 2022, 8, 368. [Google Scholar] [CrossRef] [PubMed]
- Tatebayashi, K.; Yamamoto, K.; Tomida, T.; Nishimura, A.; Takayama, T.; Oyama, M.; Kozuka-Hata, H.; Adachi-Akahane, S.; Tokunaga, Y.; Saito, H. Osmostress enhances activating phosphorylation of Hog1 MAP kinase by mono-phosphorylated Pbs2 MAP 2K. EMBO J. 2020, 39, e103444. [Google Scholar] [CrossRef] [PubMed]
- Aluru, M.; McKinney, T.; Venero, A.-K.L.; Choudhury, S.; Torres, M. Mitogen-activated protein kinases, Fus3 and Kss1, regulate chronological lifespan in yeast. Aging 2017, 9, 2587–2609. [Google Scholar] [CrossRef] [PubMed]
- Matheis, S.; Yemelin, A.; Scheps, D.; Andresen, K.; Jacob, S.; Thines, E.; Foster, A. Functions of the Magnaporthe oryzae Flb3p and Flb4p transcription factors in the regulation of conidiation. Microbiol. Res. 2017, 196, 106–117. [Google Scholar] [CrossRef]
- Zhou, X.; Liu, W.; Wang, C.; Xu, Q.; Wang, Y.; Ding, S.; Xu, J.-R. A MADS-box transcription factor MoMcm1 is required for male fertility, microconidium production and virulence in Magnaporthe oryzae. Mol. Microbiol. 2011, 80, 33–53. [Google Scholar] [CrossRef]
- Wei, W.; Xiong, Y.; Zhu, W.; Wang, N.; Yang, G.; Peng, F. Colletotrichum higginsianum Mitogen-Activated Protein Kinase ChMK1: Role in Growth, Cell Wall Integrity, Colony Melanization, and Pathogenicity. Front. Microbiol. 2016, 7, 1212. [Google Scholar] [CrossRef]
- Fu, T.; Shin, J.H.; Lee, N.H.; Lee, K.H.; Kim, K.S. Mitogen-activated protein kinase CsPMK1 is essential for pepper fruit an-thracnose by Colletotrichum scovillei. Front. Microbiol. 2022, 13, 770119. [Google Scholar] [CrossRef]
- Liang, X.; Wei, T.; Cao, M.; Zhang, X.; Liu, W.; Kong, Y.; Zhang, R.; Sun, G. The MAP Kinase CfPMK1 Is a Key Regulator of Pathogenesis, Development, and Stress Tolerance of Colletotrichum fructicola. Front. Microbiol. 2019, 10, 1070. [Google Scholar] [CrossRef]
- Sharmeen, N.; Sulea, T.; Whiteway, M.; Wu, C. The adaptor protein Ste50 directly modulates yeast MAPK signaling specificity through differential connections of its RA domain. Mol. Biol. Cell 2019, 30, 794–807. [Google Scholar] [CrossRef] [PubMed]
- Park, G.; Xue, C.; Zhao, X.; Kim, Y.; Orbach, M.; Xu, J.-R. Multiple Upstream Signals Converge on the Adaptor Protein Mst50 in Magnaporthe grisea. Plant Cell 2006, 18, 2822–2835. [Google Scholar] [CrossRef] [PubMed]
- Zhao, Y.-L.; Zhou, T.-T.; Guo, H.-S. Hyphopodium-Specific VdNoxB/VdPls1-Dependent ROS-Ca2+ Signaling Is Required for Plant Infection by Verticillium dahliae. PLoS Pathog. 2016, 12, e1005793. [Google Scholar] [CrossRef] [PubMed]

| Variables | Statistics |
|---|---|
| Genome size (Mb) | 50.74 |
| Number of scaffolds | 8 |
| Scaffold N50 size (Mb) | 7.26 |
| GC content (%) | 50.14% |
| Number of predicted genes | 16455 |
| Average gene length (bp) | 665 |
| Number of predicted secreted proteins | 1884 |
| BUSCO 1 completeness (%) | 99.8% |
Disclaimer/Publisher’s Note: The statements, opinions and data contained in all publications are solely those of the individual author(s) and contributor(s) and not of MDPI and/or the editor(s). MDPI and/or the editor(s) disclaim responsibility for any injury to people or property resulting from any ideas, methods, instructions or products referred to in the content. |
© 2023 by the authors. Licensee MDPI, Basel, Switzerland. This article is an open access article distributed under the terms and conditions of the Creative Commons Attribution (CC BY) license (https://creativecommons.org/licenses/by/4.0/).
Share and Cite
Yan, X.; Zhang, S.; Yu, Z.; Sun, L.; Sohail, M.A.; Ye, Z.; Zhou, L.; Qi, X. The MAP Kinase PvMK1 Regulates Hyphal Development, Autophagy, and Pathogenesis in the Bayberry Twig Blight Fungus Pestalotiopsis versicolor. J. Fungi 2023, 9, 606. https://doi.org/10.3390/jof9060606
Yan X, Zhang S, Yu Z, Sun L, Sohail MA, Ye Z, Zhou L, Qi X. The MAP Kinase PvMK1 Regulates Hyphal Development, Autophagy, and Pathogenesis in the Bayberry Twig Blight Fungus Pestalotiopsis versicolor. Journal of Fungi. 2023; 9(6):606. https://doi.org/10.3390/jof9060606
Chicago/Turabian StyleYan, Xiujuan, Shuwen Zhang, Zheping Yu, Li Sun, Muhammad Aamir Sohail, Zihong Ye, Lei Zhou, and Xingjiang Qi. 2023. "The MAP Kinase PvMK1 Regulates Hyphal Development, Autophagy, and Pathogenesis in the Bayberry Twig Blight Fungus Pestalotiopsis versicolor" Journal of Fungi 9, no. 6: 606. https://doi.org/10.3390/jof9060606
APA StyleYan, X., Zhang, S., Yu, Z., Sun, L., Sohail, M. A., Ye, Z., Zhou, L., & Qi, X. (2023). The MAP Kinase PvMK1 Regulates Hyphal Development, Autophagy, and Pathogenesis in the Bayberry Twig Blight Fungus Pestalotiopsis versicolor. Journal of Fungi, 9(6), 606. https://doi.org/10.3390/jof9060606

